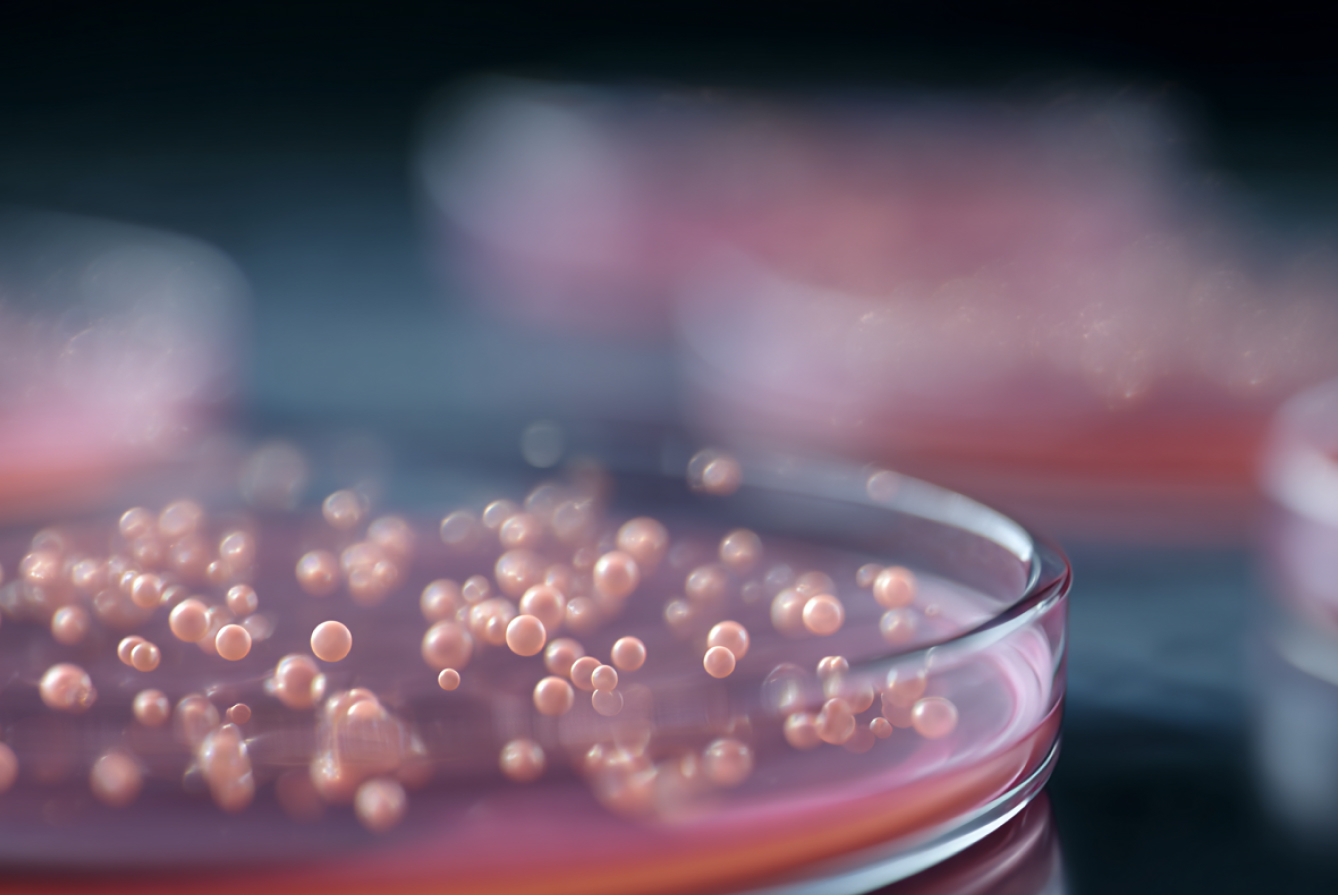

Категории анализов
 Плазминоген
775 руб
Плазминоген
775 руб
 Поверхностный антиген вируса гепатита В (австралийский антиг...
370 руб
Поверхностный антиген вируса гепатита В (австралийский антиг...
370 руб
 Посев мочи на флору с определением чувствительности к основн...
1 470 руб
Посев мочи на флору с определением чувствительности к основн...
1 470 руб
Посев мочи на флору с определением чувствительности к расшир...
2 100 руб
Посев мочи на флору с определением чувствительности к расшир...
2 100 руб
 Посев на возбудителей кишечной инфекции (сальмонеллы, шигелл...
1 285 руб
Посев на возбудителей кишечной инфекции (сальмонеллы, шигелл...
1 285 руб
 Посев на микрофлору отделяемого ЛОР-органов с определением ч...
1 260 руб
Посев на микрофлору отделяемого ЛОР-органов с определением ч...
1 260 руб
 Посев на микрофлору отделяемого урогенитального тракта женщи...
1 250 руб
Посев на микрофлору отделяемого урогенитального тракта женщи...
1 250 руб
 Прогестерон
380 руб
Прогестерон
380 руб
 Прогностическая вероятность (значение ROMA, постменопауза) (...
1 900 руб
Прогностическая вероятность (значение ROMA, постменопауза) (...
1 900 руб
 Прогностическая вероятность (значение ROMA, пременопауза) (в...
1 900 руб
Прогностическая вероятность (значение ROMA, пременопауза) (в...
1 900 руб
 Прокальцитонин
1 985 руб
Прокальцитонин
1 985 руб
 Пролактин
400 руб
Пролактин
400 руб
Сдавайте комплексом!
Все комплексы ›
Консультация специалиста
Нужна помощь службы заботы?
Оставьте заявку — специалист IZILAB свяжется с вами в ближайшее время
- Оформление заказа
- Помощь и пояснения относительно информации по анализам
- Вопросы по работе сайта
- Грамотный подбор нужного комплекса анализов с максимальной выгодой
Или задайте ваш вопрос в мессенджерах
Отвечаем ежедневно с 8.00 до 22.00


















